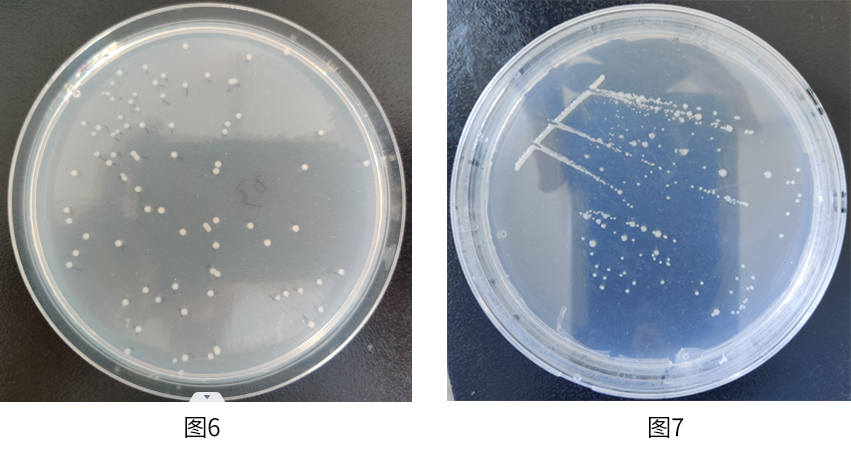
圖片6-7.jpg

一���、氮素的固定方式和形式
氮素的固定方式有生物固氮���、閃電固氮���、工業(yè)固氮,其中生物固氮是指有固氮酶的微生物在常溫常壓下將空氣中的氮氣還原成NH3的過程(圖1)�����。生物固氮量約達工業(yè)固氮量的3倍�����,約占總固氮量的65~70%,在自然界氮循環(huán)中起重要的作用(圖1)�。其化學(xué)反應(yīng)式簡寫為: N2+8H++8e-+16ATP→2NH3+H2+16ADP+16Pi����。

圖1 氮循環(huán)
生物固氮有三種形式:自生固氮�����、聯(lián)合固氮����、共生固氮��。微生物在土壤中獨立生活�,獨立進行固氮的方式稱自生固氮(圖2)��;微生物在植物體腔或根際生活�,不形成特殊器官,但可為植物提供氮素的固氮過程叫聯(lián)合固氮(圖3)��。微生物與植物互利共生形成根瘤�����,在根瘤中的固氮過程叫共生固氮(圖4����、,圖5)。其中共生固氮效率最高���、分布最廣����,其固氮量占生物固氮的80%���。

圖2 自生固氮菌(圓核固氮菌) 圖3 聯(lián)合固氮菌(巴西固氮螺菌)

圖4 共生固氮菌(大豆根瘤菌) 圖5 根瘤菌和大豆共生結(jié)瘤
二�、農(nóng)作物生長的氮素來源
自然界中的氮絕大部分以單質(zhì)分子N2存在于大氣中�����,不能被植物直接吸收利用。工業(yè)生產(chǎn)氮肥就是將氮氣轉(zhuǎn)化的方式之一�,農(nóng)業(yè)生產(chǎn)對氮肥的需求逐年增加。1913年�����,Haber-Bosch發(fā)明了在高溫高壓催化N2轉(zhuǎn)化為NH3的化學(xué)方法來生產(chǎn)氮肥���,世界各國大量投資生產(chǎn)工業(yè)氮肥���,為達到預(yù)期的糧食產(chǎn)量��,化肥消耗的年增長率達0.7%-1.3%。特別是我國���,化肥的生產(chǎn)量和使用量都居世界首位���,使用量約是澳大利亞的8倍、美國的3倍��。但是化肥過量使用帶來了一系列問題��,比如化肥利用率降低�,僅35%或更低�,造成環(huán)境污染���,使土壤板結(jié)和肥力下降,給能源供給造成很大壓力等�����。
相比工業(yè)固氮�����,生物固氮不僅固氮量巨大��,而且廉價���、無污染��、能減少化肥的用量和節(jié)約能源力等����,是未來農(nóng)業(yè)生產(chǎn)節(jié)本增效的有效手段�,也是將來現(xiàn)代化農(nóng)業(yè)生產(chǎn)的主要氮源之一�����。
三、共生固氮在農(nóng)業(yè)生產(chǎn)中的應(yīng)用
中國古代的勞動人民很早就知道種植大豆可以提高土壤肥力��,人們用豆科植物和其他非豆科植物輪作來提高農(nóng)作物產(chǎn)量����、改良土壤環(huán)境。在100多年前人們就明確地利用根瘤菌接種豆科植物來提高產(chǎn)量,1886年H.Hellrigel發(fā)現(xiàn)和證明了根瘤菌具有共生固氮作用��。波蘭學(xué)者Prazmoski于1889年率先用根瘤菌接種豆科植物,并獲得成功����。
如今,世界各國積極進行根瘤菌接種劑的開發(fā)應(yīng)用�,對生物固氮分子機制的不斷認(rèn)識也加快了生產(chǎn)應(yīng)用研究��。在當(dāng)今環(huán)境污染�����、資源短缺��、生態(tài)環(huán)境破壞嚴(yán)重的形勢下���,開發(fā)根瘤菌這一綠色生態(tài)的生物氮肥����,顯得更為重要�。
目前國內(nèi)外根瘤菌菌劑產(chǎn)品主要集中在經(jīng)濟作物大豆和花生上��,坤禾生物菌種庫里有多株不同來源的大豆和花生根瘤菌菌種(圖6����、圖7),坤禾生物技術(shù)團隊?wèi){借多年扎實的根瘤菌研發(fā)技術(shù)積累和沉淀���,在菌株的篩選、功能驗證�、菌種的發(fā)酵和規(guī)?�;a(chǎn)�、田間應(yīng)用方面具有規(guī)范成熟的配套體系和方案����,適應(yīng)目前我國大豆和花生固氮根瘤菌的大面積推廣應(yīng)用的急迫形勢�����。
圖6 大豆根瘤菌 圖7 花生根瘤菌